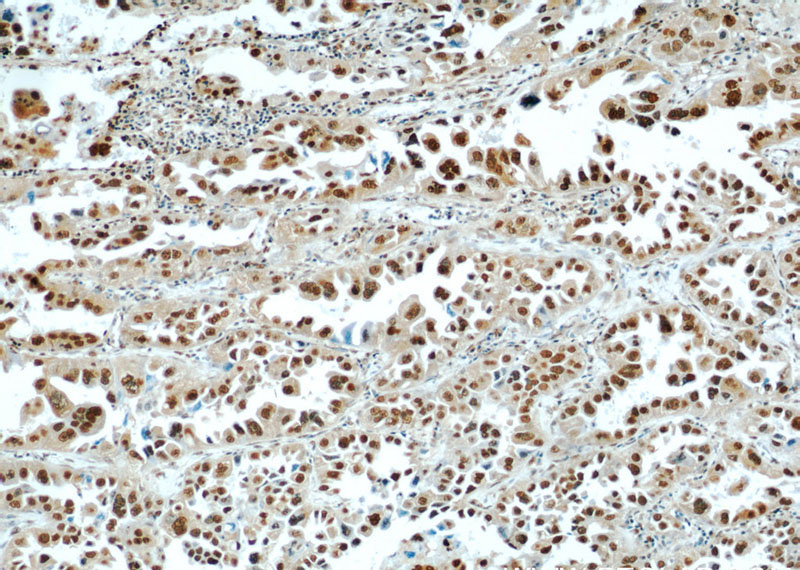
Immunohistochemical of paraffin-embedded human lung cancer using Catalog No:111386(HDGF antibody) at dilution of 1:100 (under 10x lens)
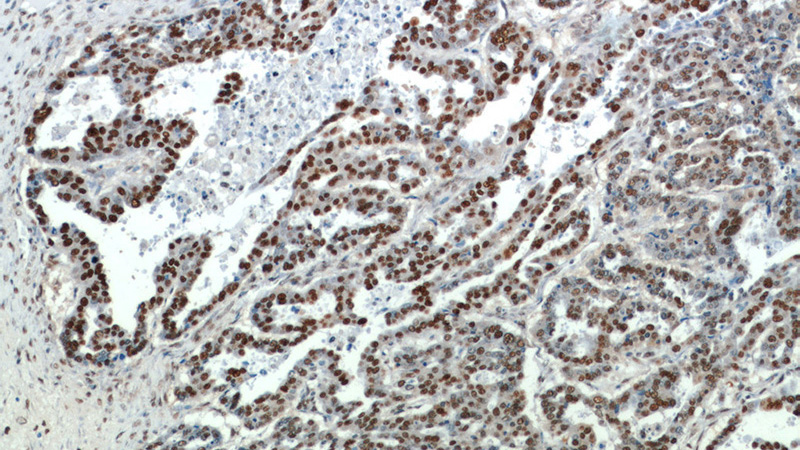
Immunohistochemical of paraffin-embedded human ovary tumor using Catalog No:111386(HDGF antibody) at dilution of 1:100 (under 10x lens)

-
Product Name
HDGF antibody
- Documents
-
Description
HDGF Rabbit Polyclonal antibody. Positive IF detected in HeLa cells. Positive IHC detected in human lung cancer tissue, human colon cancer tissue, human liver cancer tissue, human ovary tumor tissue. Positive WB detected in HeLa cells, A549 cells, HepG2 cells. Positive IP detected in HepG2 cells. Observed molecular weight by Western-blot: 40 kDa
-
Tested applications
ELISA, IP, WB, IHC, IF
-
Species reactivity
Human; other species not tested.
-
Alternative names
DKFZp686J1764 antibody; FLJ96580 antibody; HDGF antibody; Hepatoma derived growth factor antibody; HMG 1L2 antibody; HMG1L2 antibody
-
Isotype
Rabbit IgG
-
Preparation
This antibody was obtained by immunization of HDGF recombinant protein (Accession Number: NM_004494). Purification method: Antigen affinity purified.
-
Clonality
Polyclonal
-
Formulation
PBS with 0.1% sodium azide and 50% glycerol pH 7.3.
-
Storage instructions
Store at -20℃. DO NOT ALIQUOT
-
Applications
Recommended Dilution:
WB: 1:1000-1:10000
IP: 1:500-1:5000
IHC: 1:20-1:200
IF: 1:50-1:500
-
Validations

HeLa cells were subjected to SDS PAGE followed by western blot with Catalog No:111386(HDGF antibody) at dilution of 1:2000

IP Result of anti-HDGF (IP:Catalog No:111386, 3ug; Detection:Catalog No:111386 1:1000) with HepG2 cells lysate 3000ug.

Immunohistochemical of paraffin-embedded human lung cancer using Catalog No:111386(HDGF antibody) at dilution of 1:100 (under 40x lens)
Immunohistochemical of paraffin-embedded human lung cancer using Catalog No:111386(HDGF antibody) at dilution of 1:100 (under 10x lens)

Immunohistochemical of paraffin-embedded human ovary tumor using Catalog No:111386(HDGF antibody) at dilution of 1:100 (under 40x lens)

Immunofluorescent analysis of (10% Formaldehyde) fixed HeLa cells using Catalog No:111386(HDGF Antibody) at dilution of 1:50 and Alexa Fluor 488-congugated AffiniPure Goat Anti-Rabbit IgG(H+L)
Immunohistochemical of paraffin-embedded human ovary tumor using Catalog No:111386(HDGF antibody) at dilution of 1:100 (under 10x lens)
-
Background
HDGF, also named as HMG1L2, belongs to the HDGF family. HDGF is a mitogen for many cell types with nuclear localization necessary for its mitogenic activity. HDGF has also been identified as an important prognostic marker in pathologic cell growth, as it is overexpressed in a number of cancers with expression linked to a poor outcome in lung, esophageal, pancreatic and hepatic cancer.HDGF is highly expressed in human NSCLC tissues, predicting worse prognosis in resected NSCLCs. It might be useful molecular biomarker for predicting the prognosis of resected NSCLCs.
-
References
- Zhou Y, Zhou N, Fang W, Huo J. Overexpressed HDGF as an independent prognostic factor is involved in poor prognosis in Chinese patients with liver cancer. Diagnostic pathology. 5:58. 2010.
- Wang S, Fang W. Increased expression of hepatoma-derived growth factor correlates with poor prognosis in human nasopharyngeal carcinoma. Histopathology. 58(2):217-24. 2011.
- Li YL, Ye F, Cheng XD. Identification of glia maturation factor beta as an independent prognostic predictor for serous ovarian cancer. European journal of cancer (Oxford, England : 1990). 46(11):2104-18. 2010.
- Li D, Han Z, Liu J. Upregulation of nucleus HDGF predicts poor prognostic outcome in patients with penile squamous cell carcinoma bypass VEGF-A and Ki-67. Medical oncology (Northwood, London, England). 30(4):702. 2013.
- Wang L, Jiang Q, Hua S. High nuclear expression of HDGF correlates with disease progression and poor prognosis in human endometrial carcinoma. Disease markers. 2014:298795. 2014.
- Liu Y, Sun J, Yang G. Downregulation of the expression of HDGF attenuates malignant biological behaviors of hilar cholangiocarcinoma cells. Molecular medicine reports. 12(3):4713-9. 2015.
- Cui R, Zhang H, Guo X, Cui Q, Wang J, Dai J. Proteomic analysis of cell proliferation in a human hepatic cell line (HL-7702) induced by perfluorooctane sulfonate using iTRAQ. Journal of hazardous materials. 299:361-70. 2015.
- Liu YF, Zhao R, Guo S. Expression and clinical significance of hepatoma-derived growth factor as a prognostic factor in human hilar cholangiocarcinoma. Annals of surgical oncology. 18(3):872-9. 2011.
Related Products / Services
Please note: All products are "FOR RESEARCH USE ONLY AND ARE NOT INTENDED FOR DIAGNOSTIC OR THERAPEUTIC USE"
